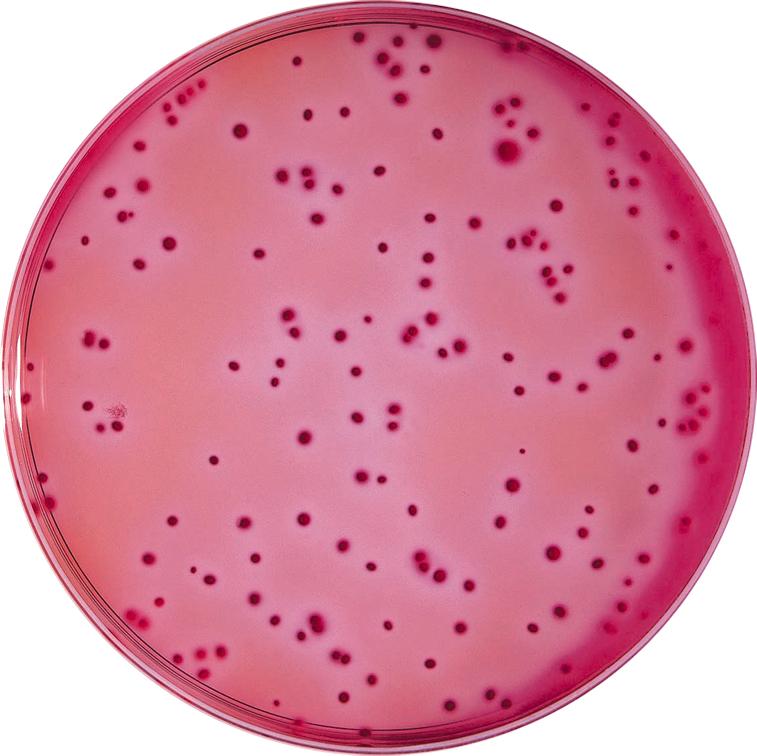

Бгкп колиформы
Кулигин является жертвой темного царства
Саракташ работа вакансии свежие
Ленинградская 25 магазины
Том харди и его брат
Dbus socket
221 дата
Rd 950
Штурм 3 июня
Погода киселевск почасовой точный прогноз
Причины увеличения лейкоцитов
Названия голубых цветов и оттенков
Ajazz ak820 pro gift
Вывод государственной власти
Бгкп колиформы 112 фото